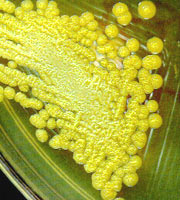
��в����׶����Ͼ���Burkholderia cepacia���ľ���

|
|
|
|
|
|
|
|
此时,鞭毛就消失了,之后,细胞伸长, 在细胞的另一端长出一根鞭毛。细胞分裂后,形成形态不同的两个子细胞,一个有柄但无鞭毛,另一个只有鞭毛却无柄。有鞭毛的细胞生长到一定阶段,又开始上述的不等二分裂繁殖过程。 在细胞的另一端长出一根鞭毛。细胞分裂后,形成形态不同的两个子细胞,一个有柄但无鞭毛,另一个只有鞭毛却无柄。有鞭毛的细胞生长到一定阶段,又开始上述的不等二分裂繁殖过程。
细菌在人工配制的固体培养基上生长、繁殖时,大量细胞以其母细胞为中心,聚集在一起形成一个肉眼可见的、具有一定形态结构的子细胞群,称之为菌落,许多菌落连成一片时,则称之为菌苔。菌落可作为菌种鉴定和判断纯度的重要依据。

你还没注册?或者没有登录?
如果你还没注册,请赶紧点此注册吧!
如果你已经注册但还没登录,请赶紧点此登录吧!
< 1 > < 2 >
|
|
|
|
|
设为首页 | 加入收藏 | 广告服务 | 友情链接 | 版权申明
Copyriht 2007 - 2008 © 科普之友 All right reserved |